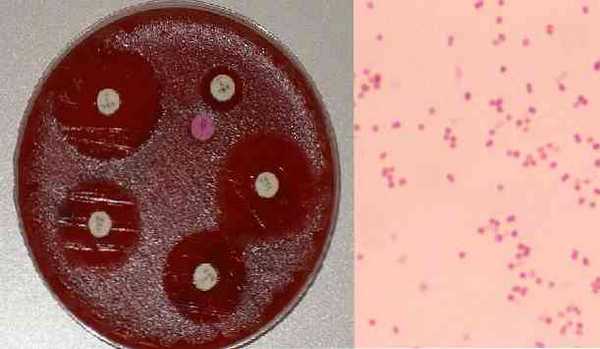

Бранхамеллы. Бактерии подрода Branhamella. Свойства бактерий рода бранхамелла. Особенности бактерий подрода Branhamella.
Добавил пользователь Алексей Ф. Обновлено: 22.01.2026
Moraxella это род, который включает виды бактерий, принадлежащих к нормальной микробиоте носоглотки и, в меньшей степени, половых путей. Иногда его представители могут действовать как условно-патогенные микроорганизмы, поскольку некоторые из его видов были выделены как этиологические агенты нозокомиальных инфекций, инфицированных ран, пневмонии, системных инфекций и других.
Основной вид этого рода - Moraxella catarrhalis, который также был известен под названием Бранхамелла катаральная. Считается третьим по значимости возбудителем в дыхательных путях после Пневмококк Y Haemophilus influenzae.
Есть и другие виды, такие какMoraxella atlantae, M. boevrei, M. bovis, M. canis, M. caprae, M. caviae, M. cuniculi, M. equi, M. lacunata, M. lincolnii, M. nonliquefaciens, M. oblonga, M. osloensis , M. saccharolytica Y M. phenylpyruvica.
Из этих видов наиболее клинически важными являются Moraxella catarrhalis, M. lacunata, M. nonliquefaciens, M. osloensis, M. atlantae и M. phenylpyruvica.
Некоторые штаммы предназначены исключительно для животных, таких какМ. bovis, М. canis, М. caprae.В прошлом эти штаммы были очень чувствительны к пенициллину, однако в настоящее время известны случаи, когда виды Moraxella продуцируют бета-лактамазы.
характеристики
Все виды рода Moraxella они аэробны, неподвижны, имеют фимбрии, не производят пигмента или гемолиза в кровяном агаре.
Они положительны на оксидазу и каталазу, важные тесты для дифференциации пола. Moraxella других морфологически очень близких родов. Например, оксидаза помогает исключить пол. Acinetobacter,а каталаза исключает род Kingella.
Еще один род, с которым их можно спутать, особенно виды М. catarrhalis, это с Нейссерия, как по морфологии, так и по оксидазному тесту.
В этом случае они различаются по недееспособности по полу. Moraxella образовывать кислоту из углеводов, в то время как большая часть Neisseria если они способны сбраживать углеводы.
Еще один способ различить пол Neisseria жанра Moraxella заключается в окрашивании по Граму путем взятия колоний с внешнего края зоны ингибирования вокруг пенициллинового диска.
Виды Neisseria полностью кокковидные и Moraxella они получат удлиненные плеоморфные формы. В свою очередь, М. фенилпирувика Он характеризуется гидролизом мочевины и дезаминированием фенилаланина.
Moraxella catarrhalis Он характеризуется образованием ДНКазы, гидролизом трибутирина и восстановлением нитратов до нитритов.
Развитие
Для правильного развития этим бактериям необходимы определенные условия, например присутствие кислорода, поскольку они строго аэробны. Точно так же им нужны диапазоны температур, которые колеблются от 30 ° C до 37 ° C, а значения pH - от 5,0 до 9,0.
Биохимия
С биохимической точки зрения эти бактерии обладают следующими характеристиками:
- Каталаза положительная. Это означает, что они синтезируют фермент каталазу, который катализирует реакцию расщепления молекулы пероксида водорода (H2O2) на кислород и воду.
- Положительная оксидаза. Это означает, что посредством аэробного метаболизма и синтеза фермента цитохром-с-оксидазы они используют кислород для получения энергии через цепь переноса электронов во время клеточного дыхания.
- Положительная уреаза. Эти бактерии синтезируют фермент уреазу. Этот фермент позволяет гидролизу молекулы мочевины до аммиака (NH3) и диоксид углерода.
Морфология
Бактерии, принадлежащие к роду Moraxella Это короткие полоски, которые выглядят коренастыми. Точно так же они могут быть представлены цепочками или парами. Их средний размер составляет 1,0-1,5 мкм в ширину и 1,5-2,5 мкм в длину.
Колонии наблюдаются в культурах, которые имеют гладкую текстуру и могут быть непрозрачными или полупрозрачными. Они выглядят как небольшие ямки на поверхности питательной среды.
Пол Moraxella при окраске по Граму они могут быть видны как грамотрицательные диплобациллы, коккобациллы или диплококки, в зависимости от вида. В частном случае Moraxella catarrhalis, это единственный вид, который имеет грамотрицательную диплококковую морфологию.
Макроскопически через 24 часа инкубации на кровяном агаре наблюдаются небольшие точечные колонии серого цвета размером менее 0,5 мм в диаметре.
С другой стороны, большинство штаммов рода Moraxella растут медленно и медленно на агаре МакКонки с не ферментирующими лактозу (бледными) колониями, в то время как другие просто не растут как M. lacunata Y М. nonliquefaciens.
Некоторые виды
Некоторые виды рода упомянуты ниже. Moraxella и его макроскопические или культурные характеристики.
Moraxella atlantae он медленно растет в культуральной среде и образует колонии со склонностью к образованию инвазивной зоны после 48 часов инкубации.
Со своей стороны, Moraxella lacunata требует особых требований к культуре, таких как обогащенная среда без пептона, добавление олеиновой кислоты или кроличьей сыворотки для противодействия протеолитическому токсическому эффекту. Растет на кровяном агаре в виде укуса.
Moraxella nonliquefaciens Вам также нужны сывороточные добавки для оптимального развития, и они выделяются, потому что их колонии очень слизистые.
Moraxella osloensis и M. phenylpyruvica к их утеплению не требуются особые требования.
Moraxella canis дает большие гладкие колонии на агаре с овечьей кровью, похожие на семейные Энтеробактерии.
Таксономия
Класс: Протеобактерии гамма
Передача инфекции
Не ясно, но считается, что виды рода Moraxella Они могут передаваться от человека к человеку через аэрозоли или через источники окружающей среды.
Основные виды
Moraxella Это род, состоящий из 15 видов. Большинство из них присутствует у различных животных. Тот, который чаще всего вызывает патологии у людей, - это Moraxella catarrhalis. Из-за своего воздействия на здоровье человека это вид, который изучен наиболее тщательно. Однако в этом роде есть и другие важные виды, такие как Moraxella canis Y Moraxella bovis.
Moraxella catarrhalis
Его название происходит от греческого слова katarrhein, которое означает «дренировать», имея в виду выделения из носа, наблюдаемые при инфекциях, вызываемых этими бактериями у людей.
Обычно он встречается в виде кокков, образующих пары, то есть в виде диплококков. Это строго аэробный организм, поэтому для развития ему требуется среда, богатая кислородом. Точно так же он является оксидазо-положительным.
Эта бактерия уникальна для человека. В них он в основном заселяет дыхательные пути. Несмотря на это, в некоторых случаях (очень немного) он был изолирован от половых путей. Было установлено, что дети являются наиболее распространенными хозяевами, представляя 75% переносчиков бактерий по сравнению со взрослыми.
Любопытен тот факт, что распространенность этой бактерии становится более очевидной в осенне-зимний период.
Среди инфекций, которые он вызывает у людей, можно упомянуть: синусит, средний отит, пневмонию (особенно у пожилых) и другие инфекции нижних дыхательных путей.
Moraxella canis
Это бактерия, которая, как и другие представители этого рода Moraxella, является грамотрицательным, каталазным и оксидазным положительным. Он находится в основном как часть нормальной микробиоты ротовой полости собак.
Эта бактерия очень хорошо растет на кровяном агаре и шоколадном агаре. Он может передаваться человеку через укус или когда собака проводит языком по ране на человеке. Несмотря на это, было описано очень мало случаев заражения людей. Moraxella canis.
Moraxella bovis
Эти бактерии имеют разнообразную морфологию, они могут выглядеть как кокки или бациллы. Точно так же они могут быть обнаружены парами или короткими цепочками и характеризуются наличием гемолитического фактора, который производит дермонекротоксин, который считается фактором патогенности. Точно так же они грамотрицательные, а также строгие аэробы.
В области ветеринарии это хорошо изученная бактерия, поскольку она напрямую поражает крупный рогатый скот (коров), вызывая определенные инфекции, такие как инфекционный кератит крупного рогатого скота или конъюнктивит. Считается, что мухи являются основными переносчиками бактерий от больного животного к здоровому.
Moraxella phenylpyruvica
Этот вид обычно не является патогенным, но сообщалось о спорадических случаях синусита, конъюнктивита, септического артрита, остеомиелита, перитонита, бронхита, менингита, эндокардита, инфекции центральных венозных катетеров и сепсиса.
Moraxella lacunata
Он был изолирован от глазных инфекций (конъюнктивита), но также замечено, что он вызывает кератит, хронический синусит и эндокардит.
Moraxellanonliquefaciens
Он является частью нормальной микробиоты верхних дыхательных путей человека и часто выделяется из носовой полости.
Однако он был обнаружен в крови (сепсис), глазных выделениях (эндофтальмит), спинномозговой жидкости (менингит), нижних дыхательных путях (пневмония), септическом артрите и других местах.
Moraxella osloensis
Он был обнаружен у пациентов с бактериемией, менингитом, перитонитом, пиомиозитом, остеомиелитом, артритом, эндольфтальмитом, уретритом, вагинитом и диареей.
Moraxella atlantae
Он редко встречается при бактериемии.
Moraxella nonliquefaciens
Moraxella nonliquefaciens колонизирует в верхних дыхательных путях у людей и иногда ассоциируется с такими инфекциями, как пневмония, глазные инфекции и ринит.
Заболевания / патологии
Некоторые виды рода Moraxella Они считаются патогенными для человека и вызывают определенные инфекции на респираторном, слуховом и глазном уровнях.
Важно подчеркнуть, что, если эти инфекции не лечить должным образом, у пациента может возникнуть бактериемия, через которую бактерии могут попасть в кровь человека и вызвать серьезные повреждения, такие как эндокардит.
Средний отит
Это вызвано Moraxella catarrhalis и это чаще наблюдается у детей, чем у взрослых.
Среди наиболее частых симптомов - боль в ухе и жар. Иногда может наблюдаться отток жидкости из уха. Также часто возникают проблемы с головокружением и заложенностью носа.
Синусит
Это инфекция, которая возникает на уровне придаточных пазух носа, стенки которых инфицированы такими бактериями, как Moraxella catarrhalis. Это достаточно болезненное и неприятное состояние.
К характерным симптомам этой патологии относятся: заложенность или заложенность носа, боль и воспаление в области вокруг глаз, щек, носа или лба. Боль усиливается, когда человек опускает голову. Также может возникнуть головная боль, давление в ушах, жар и даже неприятный запах изо рта (неприятный запах изо рта).
Пневмония
Пневмония - это инфекция, которая локализуется на уровне альвеол и заставляет их заполняться жидкостью, которая может иметь гнойный характер (гной). У людей с хрупкой иммунной системой, таких как дети и пожилые люди, это может быть серьезным.
Основными симптомами этого заболевания являются кашель с отхаркиванием, одышка, боль в груди при дыхании или кашле, повышение температуры тела, повышенное потоотделение и озноб.
Конъюнктивит
Он состоит из инфекции прозрачной оболочки глаза, конъюнктивы. Это вызвано в основном бактериальными агентами, такими как некоторые представители рода Moraxella. Это очень неприятная инфекция, которая может даже мешать зрению.
Люди с конъюнктивитом испытывают зуд в пораженном глазу, ощущение песка, гнойные выделения, которые могут стать твердыми и блокировать открытие глаза, и, конечно же, покраснение и воспаление глаза.
Чувствительность к антибиотикам
Поскольку эти виды были очень чувствительны к пенициллину, не было необходимости проводить антибиотикограмму. Однако известно, что с 1990 г. большинство штаммов, особенно видов катаральный, являются продуцентами бета-лактамаз.
Поэтому желательно провести тесты на чувствительность к противомикробным препаратам. Но эту работу выполнить сложно, поскольку CLSI не указывает точки отсечения для пола. Moraxella, что затрудняет его интерпретацию.
По этой причине в некоторых лабораториях используются точки отсечки, описанные для Haemophilus influenzae или для непривередливых бактерий, которые могут расти на среде Müeller Hinton без добавок, или для неферментирующих грамотрицательных палочек.
Штаммы Moraxella catarrhalis они часто чувствительны к хинолонам, амоксициллин-клавулановой кислоте, цефалоспоринам, тикарциллину, пиперациллину, макролидам, хлорамфениколу и аминогликозидам.
Однако сообщалось о штаммах, устойчивых к тетрациклину, эритромицину, фторхинолону, макролидам, пиперациллину и некоторым цефалоспоринам.
Бранхамеллы. Бактерии подрода Branhamella. Свойства бактерий рода бранхамелла. Особенности бактерий подрода Branhamella.
Медицинская микробиология:
Клиника инфекции вызванной моракселлой (Moraxella (Branhamella) catarrhalis)
М. catarrhalis, как представитель нормальной флоры, встречается в носоглотке большинства (до 50-75%) маленьких детей, а среди взрослых — лишь у 1-5%. По всей вероятности, с возрастом снижению колонизации слизистых оболочек способствует накопление местных антител. Как и при всех капельных инфекциях, носительство наиболее распространено в холодное время года и чаще встречается у детей, посещающих детские учреждения, нежели у «домашних» детей.
У взрослых носительство чаще встречается при заболеваниях респираторного тракта, например, при бронхоэктазах, хронических бронхолегочных инфекциях, вызванных другими патогенами.
Но в отдельных случаях комменсал М. catarrhalis может быть этиологическим агентом воспалительного процесса — как самостоятельно, так и в ассоциации с другими патогенами дыхательного тракта (пневмококки, стрептококки, стафилококки, гемофилы и др.). Это наблюдается преимущественно среди детей, престарелых и лиц, имеющих различные предрасполагающие факторы.
Синусит, вызванный М. catarrhalis, осложняет до 5-10% случаев воспаления верхних дыхательных путей у детей 0-2 лет. Воспаление среднего уха у маленьких детей в 25-40 % случаев также бывает вызвано М. catarrhalis. У детей описаны конъюнктивит и даже кератит, вызванные этим возбудителем.
У взрослых, напротив, заболевания, связанные с М. catarrhalis, встречаются редко. Моракселлу выделяют при ларингитах, трахеобронхитах. Случаи пневмонии возникают чаще у пожилых, нередко как проявление внутрибольничной инфекции, особенно при хронических обструктивных заболеваниях легких. При трахеобронхите мокрота имеет гнойный характер. Пневмония, вызванная одной лишь М. catarrhalis, а не в ассоциации с другими патогенами, протекает не тяжело и обычно выявляется только при рентгеновском исследовании.
В целом, М. catarrhalis занимает третье место после S. pneumoniae и Н. influenzae, как возбудитель воспалительных заболеваний респираторного тракта и связанных с ним полостей.
В случае пневмонии, вызванной М. catarrhalis (одной или в ассоциациях), может возникнуть бактериемия, и даже сепсис. При этом появляется петехиальная сыпь, напоминающая таковую при менингококковом сепсисе. В основе сыпи лежит действие эндотоксина (ДОС), высвобождающегося при массивном размножении бактерий и их гибели. В редчайших случаях встречаются эндокардиты и даже гнойные менингиты. Летальность при бактериемии, в зависимости от тяжести ее течения и предрасполагающих условий, отмечена в пределах 13-20%.
Заболевания, вызванные М. catarrhalis, не отличаются четкой специфической клинической картиной от сходных заболеваний, вызванных другими бактериальными патогенами. Следует помнить, что в большинстве случаев бронхолегочной инфекции М. catarrhalis выделяется в ассоциации с пневмококком, имеющим самостоятельное этиологическое значение.
Особенности иммунного ответа. При изучении местного иммунного ответа оказалось, что после перенесения обострения хронической обструктивной болезни легких в секрете слизистых оболочек респираторного тракта возрос уровень IgA, специфичных в отношении адгезинов Uspl и Hag, а иногда и трансферрин-связывающего белка ТЬрВ и ДОС. Полагают, что местные антитела способствуют клиренсу (очищению) слизистых оболочек от моракселл.
Системный иммунный ответ, включающий продукцию человеком провоспалительных цитокинов, запускается проникшими в клетки моракселлами путем макропиноцитоза. В сыворотке крови больных обнаруживались иммуноглобулины класса G в отношении тех же антигенов моракселл, что и при местном ответе. Антитела отличались штаммовой специфичностью.
Эпидемиологические особенности. Как уже указывалось, интерес к М. catarrhalis возрос по мере увеличения заболеваемости внутрибольничными инфекциями. Смертность и «нетипичность» М. catarrhalis-инфекций, наблюдавшиеся в стационарах, не сразу привели исследователей к мысли об этиологической значимости этого «безобидного» комменсала. Однако развитие методов диагностики, прежде всего — генетических, позволило выявить внутрибольничные вспышки в отделениях для бронхолегочных больных.
Источником оказываются как сами больные, так и носители из числа персонала. Инфекция распространяется воздушно-капельным путем. Внутрибольничному распространению М. catarrhalis способствует ее устойчивость к бета-лактамным антибиотикам (пенициллин, ампициллин, метициллин и т.д.), широко применяемым для лечения бронхолегочных больных, а также ее достаточно высокая сохраняемость во внешней среде — на предметах, испачканных мокротой, в пыли больших палат и т. д.
Микробиологическая диагностика моракселлы (Moraxella (Branhamella) catarrhalis)
Патологическим материалом, в котором могут быть обнаружены моракселлы, обычно является отделяемое воспаленных слизистых оболочек дыхательных путей, их придаточных полостей, легких, среднего уха, изредка — глаза. Это может быть мокрота, трахеальный аспират, промывные воды бронхов, и синусов, слизь из зева и носоглотки, отделяемое среднего уха, конъюнктивы глаза, перитонеальный экссудат и т. п.. В редчайших случаях М. catarrhalis высевается из крови при подозрении на бактериемию и из спинномозговой жидкости (СМЖ) при гнойном менингите.
В случаях, когда материалом является СМЖ, гнойная мокрота, гнойное отделяемое среднего уха, имеет смысл провести микроскопическое исследование. Для этого готовят препараты-мазки, окрашенные метиленовым синим и по Граму в модификации Калины. В мазках могут быть видны грамотрицательные диплококки, иногда находящиеся внутри полинуклеарных фагоцитов. Но основным методом является бактериологическое исследование.
Первый день. Вышеперечисленные варианты проб материала, за исключением крови и СМЖ, независимо от вида подозреваемого возбудителя, засевают в чашки Петри с 5%-ным кровяным агаром. Кровь засевают на среду для гемокультур, а СМЖ на среды для возбудителей гнойных менингитов — «шоколадно»-кровяной и сывороточный агары.
При повторных исследованиях материала, ранее содержавшего М. catarrhalis, для слежения за элиминацией микроорганизма можно делать посев на питательный агар, содержащий нормальную сыворотку и 5 мкг/мл линкомицина (раздел 5.6), ингибирующего рост грамположительной флоры.
Второй день. После инкубации в течение 24 часов изучают выросшие колонии. Колонии М. catarrhalis на кровяном агаре отличаются от других возможных патогенов респираторного тракта. Они хорошо развиты (не менее 1 мм в диаметре), не пигментированы, влажны, имеют ровные края и гладкую поверхность, слегка выпуклые, серовато-белого цвета, не изменяют цвет кровяного агара. На сывороточном агаре колонии матовые, бесцветные, влажные. Наличие антибиотика в среде не влияет на вид колоний, но слегка замедляет их развитие.
Из части подозрительной на моракселлу колонии делают мазок, окрашенный по Граму (лучше в модификации Г. П. Калины). В случае обнаружения грамотрицательных кокков, склонных к образованию пар, колонию отсевают для получения чистой культуры на питательный агар (без биодобавок) и инкубируют в термостате 1 сутки.
Третий день. Изучают морфологию выделенной чистой культуры. Снова проверяют на наличие желтого или желто-зеленого пигмента. Ставят пробы на оксидазу и каталазу. Грамотрицательные кокки, не образующие пигмента, оксидазо- и каталазоположительные, могут относиться к родам как Neisseria (вплоть до гонококка и менингококка), так и к Moraxella (Branhamella). Подозрение на гонококк и менингококк должно отпасть, т. к. последние неспособны развиваться на средах без биодобавок — сыворотки или крови. Однако необходимость дифференциации с непигментированными нейссериями (N. sicca, некоторые штаммы N. mucosa) остается.
Кроме того, теоретически существует необходимость дифференциации М. catarrhalis и сходных представителей других видов моракселл. Из числа последних могут встретиться М. lacunata — нормальный обитатель конъюнктивы глаза и М. nonliquefaciens, входящая в нормальную флору носа. Обе моракселлы отпадают уже на 2-й день исследования на основании морфологии колоний. У М. lacunata колонии как бы «въедаются» в агар, образуя в нем лакуны. В мазках из таких колоний видны грамотрицательные коккобактерии, располагающиеся парами и небольшими цепочками. М. nonliquefacaens образует «въевшиеся» в агар колонии или крупные (2-3 мм), слизистые, хотя клетки ее морфологически похожи на М. catarrhalis.
На простых питательных средах обе моракселлы не растут, что облегчает их дифференциацию с неприхотливой М. catarrhalis. Для дифференциации от прочих грамотрицательных кокков рекомендуют тесты, которые можно условно разделить на основные и вспомогательные.
Основные тесты:
• разложение ДНК, характерное только для М. catarrhalis (не считая Staphylococcus aureus, Corynebacterium diphtheriae, и др., отличающиеся по другим признакам);
• неспособность М. catarrhalis разлагать углеводы — глюкозу, мальтозу, сахарозу, фруктозу, лактозу (в отличие от многих, в т.ч. беспигментных нейссерий, разлагающих от 1 до 4 из этих субстратов).
Вспомогательные тесты:
• неспособность к пигментообразованию;
• способность к росту при 22°С (в отличие от патогенных и некоторых пигментных видов нейссерии);
• редукция нитратов с образованием газообразных продуктов, присущая только М. catarrhalis и N. mucosa);
• неспособность к росту на кровяном агаре в анаэробных условиях (в отличие от большинства нейссерий);
• способность к разложению трибутирина до кислых продуктов, отсутствующая у нейссерий, но встречающаяся у других видов моракселл;
• неспособность к формированию полисахарида на среде с 5% сахарозы, в отличие от многих нейссерий.
Из этих проб на 3-й день имеет смысл поставить самые простые: — отсев на среды с углеводами Хью-Лейфсона и на питательный агар для культивирования при 22°С. Кроме того, выделенная культура пересевается на скошенный агар для культивирования при 35-36°С в качестве контроля роста при 22°С, а также для дальнейшего изучения.
Четвертый день. Учитывают наличие или отсутствие изменения сред с углеводами, результаты инкубации при 22°С (в сравнении с инкубацией в термостате). Еще раз убеждаются в отсутствии пигмента у выросшей культуры. В случае отсутствия пигмента, разложения углеводов и хорошо выраженного роста при 22°С можно отнести выделенную культуру к М. catarrhalis.
Однако в случае сомнения (например, при отсутствии разложения углеводов и роста при 22°С или нечеткого пигментообразования) можно поставить и другие пробы. Как уже указывалось, нейссерии являются слабыми кислотообразователями; продуцируемые ими кислоты могут быть нейтрализованы щелочными продуктами, параллельно образующимися при разложении аминокислот питательной основы. В таких случаях нейссерия может имитировать М. catairhalis. Поэтому при сомнении имеет смысл поставить тест на ДНК-азу, специфичный только для М. catarrhalis, и на редукцию нитрата, не встречающуюся у нейссерий, кроме N. mucosa.
При сомнениях по поводу пигментообразования культуру отсевают на желточно-сывороточный агар или делают 2-3 пассажа на сывороточном агаре. В зависимости от обстоятельств (оснащенность лаборатории, наличие необходимых дифференциально-диагностических сред и т. д.) можно поставить и другие вспомогательные тесты, в т.ч. пробу с трибутирином.
Перспективным является обнаружение М. catarrhalis методами генодиагностики (ПЦР) прямо в исходном материале, не дожидаясь выделения чистой культуры.
Однако выделение чистой культуры моракселлы необходимо прежде всего для выявления спектра чувствительности микроорганизма к антибактериальным препаратам.
а) Определение чувствительности к антибиотикам. Чувствительность моракселл определяют на среде АГВ или агаре Мюллера-Хинтона диско-диффузионным методом.
б) Заключение об этиологической значимости выделенного штамма моракселлы. Выявление М. catarrhalis в патологическом материале еще не указывает на ее этиологическую роль в воспалительном процессе, если учесть, что этот микроорганизм встречается в составе нормальной флоры, причем у детей — достаточно часто. К сожалению, четкие количественные параметры для дифференциации М. catarrhalis, как возбудителя воспалительного процесса или как случайного контаминанта, не разработаны. Однако для решения этого вопроса применимы подходы, используемые при выделении из патологического материала других микроорганизмов, являющихся представителями нормальной флоры человека — коагулазоотрицательных стафилококков, недифтерийных коринебактерий, оральных стрептококков, нейссерий-комменсалов и др..
В случае выделения М. catarrhalis следует помнить, что нельзя исключить ее патогенетическую роль в бактериальных ассоциациях, когда в посевах преобладают 2-3 вида, включая моракселлу.
В пользу этиологической роли моракселлы говорит ее исчезновение при многократных исследованиях в динамике процессе лечения соответствующим антибактериальным препаратом.
Микробиологические показатели этиологической значимости моракселлы учитывают в сочетании с клиническими данными и преморбидным фоном больного.
Моракселлы (Moraxella (Branhamella) catarrhalis): морфология, биология
Семейство Moraxellaceae включает в себя грамотрицательные неподвижные кокки родов Moraxella, Acinetobacter и Psychrobacter. Свое название семейство и род получили в честь швейцарского офтальмолога Виктора Моракса (Victor Мотах).
Моракселлы являются членами нормальной флоры людей или животных, но пока только М. catarrhalis признана, как оппортунистический патоген человека, хотя есть указания на единичные случаи выделения М. lacunata и М. liquefaciens при блефароконъюнктивитах, эндокардите, септицемии, артрите.
Первоначально описанный в 1896 г. Р. Frasch и W. Kolle микроорганизм был назван Micrococcus catarrhalis. По мере накопления знаний грамотрицательные кокки были удалены из рода микрококков и в 1963 г. выделены в род Neisseria, из которого в 1970 г. вывели род Branhamella (в честь известной исследовательницы S. Е. Branham). В этот род и была включена описываемая бактерия. Позднее род был переименован в Moraxella с сохранением в скобках названия прежнего рода. В настоящее время род Moraxella (Branhamella) выведен из семейства Neisseriaceae и относится к семейству Moraxellaceae. Полное современное название микроорганизма — Moraxella (Branhamella) catarrhalis.
М. catarrhalis обитает на слизистых оболочках верхних дыхательных путей человека, в отдельных случаях захватывая эпителий придаточных полостей, бронхов, среднего уха и даже легких. Вышеупомянутые моракселлы других видов также являются нормальными обитателями верхних отделов дыхательного тракта.
а) Основные биологические свойства. Моракселлы — грамотрицательные бактерии, имеющие форму кокков размерами (1,0-1,5) х (1,5-2,0) мкм, часто располагающиеся парами. Иногда отмечают бобовидные формы клеток. Спор не образуют, жгутиков не имеют.
Клеточная стенка М. catarrhalis, как и всех грамотрицательных бактерий, состоит из трех слоев — наружной мембраны, пептидогликана и примыкающей со стороны цитоплазмы мембраны. Капсула у М. catarrhalis не выявлена.
Одним из основных компонентов клеточной стенки являются липоолигосахариды (ЛОС), частички которых (как и у Neisseriae) отрываются от клетки и попадают в окружающую среду.
В состав наружной мембраны входят разнообразные белки; 8 наиболее значимых из них (с мол. массой от 21 до 98 kDa) обозначены буквами латинского алфавита от А до Н. Кроме того, выявлены белки UspA1 и А2, а также белок UspA1H, от которых зависит вирулентность штамма. Части макромолекул этих белков выступают снаружи бактериальной клетки в виде отростков. В клеточной стенке имеются белки, связывающие железо непосредственно из жидкостей организма.
От клеточной стенки некоторых штаммов отходят пили, природа которых пока мало изучена.
М. catarrhalis растет на обычных средах, но рост заметно улучшается при добавлении сыворотки или крови. Колонии круглые, влажные, слегка выпуклые, около 1,0 мм в диаметре, бесцветные, опалесцирующие. Пигмента никогда не образуют. На кровяном агаре колонии крупнее, сероватые, негемолизирующие. На сывороточном агаре колонии матовые, влажные, 1,0-1,5 мм в диаметре. На бульоне М. catarrhalis формирует диффузный рост.
Как и все представители рода моракселл (и нейссерий) М. catarrhalis обладает оксидазой и каталазой. Она редуцирует и нитраты, и нитриты, разлагает препарат ДНК (с помощью фермента ДНК-азы), трибутирин — до кислот, но неактивна по отношению к традиционно используемым сахарам, в том числе к глюкозе, мальтозе, сахарозе, фруктозе, лактозе.
Большинство штаммов растет при температуре 22°С; оптимум — 35°С.
Оптимум pH сред при культивировании — 7,2-7,4.
М. catarrhalis — аэроб, утилизирующий кислород непосредственно из атмосферы.
1. Устойчивость. Моракселлы достаточно долго сохраняются во внешней среде в капельках слюны и мокроты. Они чувствительны к действию обычно применяемых дезинфектантов. Следует помнить, что значительная часть штаммов М. catarrhalis обладает устойчивостью к пенициллинам благодаря бета-лактамазам, хотя изначально этот вид относился к числу естественно чувствительных. К началу 80-х годов доля устойчивых изолятов растет в силу широкого применения этих препаратов, и к концу XX века практически все штаммы М. catarrhalis становятся резистентными. Этот микроорганизм продуцирует два типа бета-лактамаз, кодируемых хромосомными генами, которые легко переносятся чувствительным к пенициллину клетками путем конъюгации. Не исключено, что эти гены попали в популяцию моракселл от грамположительных бактерий.
В условиях широкого применения пенициллинов бета-лактамазные штаммы получили селективное преимущество перед лишенными резистентности бактериями и быстро распространились среди людей. Продуцируемая моракселлой бета-лактамаза защищает от действия пенициллина не только бактерии своего вида, но и находящихся с ними в ассоциации других обитателей слизистых оболочек (не продуцирущих бета-лактамазы), в том числе патогенные Streptococcus pneumoniae и Haemophilus influenzae, что осложняет терапию вызываемых ими инфекций.
Моракселлы чувствительны к «защищенному» пенициллину — амоксициллин/клавуланату, а также к макролидам, тетрациклинам, хлорамфениколу, цефалоспоринам 2-4 поколений, аминогликозидам и фторхинолонам.
М. catarrhalis обладает природной устойчивостью к триметоприму, ванкомицину, линкомицину, что используется при приготовлении селективных питательных сред для выделения этого вида микроорганизмов из полимикробного материала.
2. Антигенные свойства М. catarrhalis определяют липоолигосахариды (ЛОС) и белки наружной мембраны. Эти структуры достаточно консервативны и стабильны у разных штаммов, что не позволяет разделить вид на серологические разновидности — серовары. Более того, по антигенным свойствам ЛОС моракселлы сходны с таковыми у другого обитателя дыхательных путей — Н. influenzae. Этот же феномен отмечен и у железо-связывающих белков моракселл. Известно сходство некоторых белковых антигенов М. catarrhalis и менингококка.
Штаммовые различия внутри вида М. catarrhalis можно выявить только на генетическом уровне.
3. Факторы патогенности. Первый этап инфекционного процесса — колонизацию эпителия дыхательных путей человека М. catarrhalis осуществляет с помощью поверхностных белков и пилей IV типа. Пили ответственны за прикрепление к эпителию слизистой оболочки и формирование на ней биопленки, способствующей выживанию микроорганизма.
Поверхностные белки С и D обеспечивают прикрепление к муцину слизистой оболочки носоглотки и среднего уха, а также к клеткам эпителия легких. Полагают, что белки Uspl, UsplH и Usp2 участвуют в адгезии путем прикрепления к таким структурам соединительной ткани (матрикса), как фибронектин и витронектин, и также участвуют в формировании биопленки. Недавно у моракселл выявлены поверхностные белки МсаР и Hag, способствующие прикреплению к легочным клеткам. Последний белок, впрочем, препятствует образованию биопленки. Показано, что он обеспечитвает прикрепление М. catarrhalis к ресничатым клеткам бронхиального эпителия.
По некоторым данным, моракселлы все-таки способны проникать внутрь клеток бронхиального эпителия и пневмоцитов 2 типа путем макропиноцитоза, то есть захвата клеткой капли жидкости, содержащей бактерии. Значит, подобно патогенным нейссериям, М. catarrhalis является не только внеклеточным, но факультативно внутриклеточным паразитом, что способствует его патогенности.
Защитным силам организма противостоит устойчивость М. catarrhalis к действию комплемента. Замечено, что штаммы, выделенные от лиц с воспалительными явлениями, более устойчивы к уничтожению с помощью комплемента, нежели штаммы от здоровых носителей. Оказалось, что белок Usp2 связывает матричный белок человека витронектин, присоединяя его к бактериальной клетке. Соединенный с клеткой витронектин ингибирует терминальные компоненты комплемента, участвующие в образовании мембрано-атакующего комплекса, убивающего бактерию, и таким путем защищает ее от гибели.
С помощью генетических исследований показано, что вид М. catarrhalis состоит из двух генетических клонов — умеренно вирулентного и вирулентного. Именно для представителей вирулентного клона характерна устойчивость к действию комплемента и способность прикрепления к эпителию.
Известно, что М. catarrhalis нередко вызывает воспалительный процесс в ассоциации с другими бактериальными патогенами респираторного тракта — пневмококками, стрептококками, гемофилами, стафилококками, а также с микоплазмами и вирусами. При изучении этих ассоциаций выяснилось, что со Streptococcus pyogenes и с S. agalactiae (но не с другими бактериями) М. catarrhalis формирует клеточные агрегаты. Это способствует адгезии стрептококков, усиливая тем самым колонизацию эпителия этими патогенами. Так, М. catarrhalis увеличивает адгезию S. pyogenes в 10-20 раз, a S. agalactiae — в 3 раза.
Оказалось, что клетка моракселлы играет роль «посредника», адгезируясь одной своей стороной на мембране эпителия, а другой — специфически соединяясь с клеткой стрептококка. При этом моракселла снижает способность стрептококка инвазировать в эпителий, тем самым «вынуждая» его вызвать поверхностный процесс, а не глубокое поражение тканей. В адгезии моракселлы к эпителию участвуют белки UspA, но природа адгезина, ответственного за агрегацию клетки моракселлы с клеткой стрептококка, все еще неизвестна.
Фактором патогенности может оказаться ЛОС, обладающий свойствами эндотоксина и проявляющий свое действие при массивном размножении бактерий с последующим отрывом от бактериальной клетки.
Пептидогликан клеточной стенки, являющийся мощным индуктором провоспа-лительных цитокинов, напротив, может способствовать развитию антибактериальной защиты. «Самоубийственная» активность пептдогликана является, по мнению ряда исследователей, основной причиной низкой патогенности М. catarrhalis.
4. Биологические модели. Моделирование М. catarrhalis-инфекции, необходимое для изучения ее патогенеза и отработки оптимальных схем антибиоткотерапии, пока не принесло большого успеха, так как человек является единственным естественным хозяином этого микроорганизма. Созданы модели интратрахеального заражения мышей с последующим извлечением легких в различные сроки развития инфекционного процесса для последующего изучения иммунного ответа, но при этом легкие очищаются от возбудителя в течение первых же суток. Иногда удается вызвать воспалительный процесс (отит, ларингит) у крыс и шиншилл. В последнее время для изучения начальных этапов моракселла-инфекции применяют культуру клеток эпителия конъюнктивы глаза человека (клетки Chang’a).
Моракселловая характеристика, морфология, патология
Moraxella это род, который включает виды бактерий, принадлежащих к нормальной микробиоте носоглотки и в меньшей степени в половых путях. Иногда его члены могут действовать как оппортунистические патогены, потому что некоторые из их видов были выделены в качестве этиологических агентов внутрибольничных инфекций, инфицированных ран, пневмоний, системных инфекций и других..
Основным видом этого рода является Moraxella catarrhalis, который также был известен под именем Бранхамелла катаральная. Это считается третьим по значимости возбудителем на уровне дыхательных путей после Streptococcus pneumoniae и Haemophilus influenzae.
Есть и другие виды, такие как Moraxella atlantae, M. boevrei, M. bovis, M. canis, M. caprae, M. caviae, M. cuniculi, M. equi, M. lacunata, M. lincolnii, M. nonliquefaciens, M. oblonga, M. osloensis М. saccharolytica и М. фенилпирувица.
Из этих видов наиболее клинически важными являются Moraxella catarrhalis, M. lacunata, M. nonliquefaciens, M. osloensis, M. atlantae и M. phenylpyruvica.
Некоторые штаммы являются уникальными для животных, таких как M. bovis, M. canis, M. caprae. В прошлом эти штаммы были очень восприимчивы к пенициллину, однако были случаи, когда виды Moraxella продуцировали бета-лактамазы..
- 1 Характеристики
- 2 Морфология
- 2.1 Некоторые виды
- 5.1 Moraxella catarrhalis
- 5.2 Moraxella lacunata
- 5.3 Moraxella nonliquefaciens
- 5.4 Moraxella osloensis
- 5.5 Moraxella phenylpyruvica
- 5.6 Moraxella atlantae
- 5.7 Моракселла Канис
черты
Все виды рода Moraxella аэробные, неподвижные, имеют фимбрии, не продуцируют пигмент или гемолиз на агаре крови.
Они положительные оксидаза и каталаза, важные тесты для дифференциации рода Moraxella других родов морфологически очень похожи. Например, оксидаза помогает отказаться от рода Acinetobacter, и каталаза исключает род Kingella.
Другой род, с которым их можно спутать, особенно вид М. catarrhalis, Это с Neisseria, как по морфологии, так и по оксидазному тесту.
В этом случае они различаются по неспособности пола Moraxella образовывать кислоту из углеводов, в то время как большая часть Neisseria если они способны ферментировать некоторые углеводы.
Еще один способ дифференцировать пол Neisseria рода Moraxella выполнить окраску по Граму, взяв колонии от внешнего края гало ингибирования вокруг диска пенициллина.
Виды Neisseria полностью кокосовое и те из Moraxella они будут производить удлиненные, плеоморфные формы. Со своей стороны, М. фенилпирувица характеризуется гидролизом мочевины и дезаминированием фенилаланина.
Moraxella catarrhalis характеризуется продуцированием ДНКазы, гидролизом трибутирина и восстановлением нитратов до нитритов.
Пол Moraxella в граме окраска может рассматриваться как диплобациллы, коккобациллы или грамотрицательные диплококки, в зависимости от вида.
В частном случае Moraxella catarrhalis, единственный вид, имеющий грамположительную морфологию диплококков.
Макроскопически после 24 часов инкубации на кровяном агаре наблюдаются небольшие и точечные колонии диаметром менее 0,5 мм, серого цвета..
С другой стороны, большинство штаммов рода Moraxella растут с трудом и медленно на агаре Макконки с неферментирующими лактозными (бледными) колониями, тогда как другие просто не растут как М. лакуната и М. nonliquefaciens.
Некоторые виды
Вот некоторые виды рода Moraxella и его макроскопические или культурные характеристики.
Moraxella atlantae он медленно развивается в питательных средах и производит колонии с тенденцией к образованию инвазивной зоны после 48 часов инкубации.
Со своей стороны, Моракселла Лакуната Требуются особые требования к выращиванию в виде обогащенной среды без пептона, добавления олеиновой кислоты или кроличьей сыворотки для противодействия токсическому протеолитическому эффекту. Растет на кровяном агаре в виде укуса.
Moraxella nonliquefaciens также необходимы сывороточные добавки для оптимального развития и выделяются, потому что их колонии очень слизистые.
Moraxella osloensis и M. phenylpyruvica им не нужны особые требования к их изоляции.
Моракселла Канис образует большие, гладкие колонии на агаре с кровью баранов, аналогичные колонии семейства Enterobacteriaceae.
передача
Это не ясно, но считается, что виды рода Moraxella может передаваться от человека к человеку, аэрозолями или источниками окружающей среды.
патологиями
Основными патологиями, которые вызывают представители этого жанра, являются бактериемия, эндокардит, конъюнктивит, менингит и другие..
Ниже объясняются наиболее распространенные патологии, вызванные полом Moraxella в зависимости от вида.
Moraxella catarrhalis
Вызывая инфекции верхних дыхательных путей у детей и пожилых людей, и ниже у взрослых, вызывает обострения хронической обструктивной болезни легких (ХОБЛ).
Другие инфекции у взрослых, вызванные этим видом, включают:
Бактериемия, связанная с пневмонией или иммуносупрессией, перитонитом, менингитом, септическим артритом, целлюлитом, остеомиелитом, эндокардитом и перикардитом.
У детей, средний отит является распространенным из-за этой бактерии, а также синусит.
Кроме того, его часто изолируют от внутрибольничных инфекций в дыхательных путях..
Моракселла Лакуната
Он был выделен из глазных инфекций (конъюнктивит), но он также был произведен, кератит, хронический синусит и эндокардит.
Moraxella nonliquefaciens
Он является частью нормальной микробиоты верхних дыхательных путей человека и часто изолирован от полости носа..
Тем не менее, он был обнаружен в крови (сепсис), выделения из глаз (эндофтальмит), CSF (менингит), нижних дыхательных путей (пневмония), септический артрит и другие места.
Moraxella osloensis
Он был обнаружен у пациентов с бактериемией, менингитом, перитонитом, пиомиозитом, остеомиелитом, артритом, эндофтальмитом, уретритом, вагинитом и диареей..
Moraxella phenylpyruvica
Этот вид обычно не является патогенным, но сообщалось о спорадических случаях синусита, конъюнктивита, септического артрита, остеомиелита, перитонита, бронхита, менингита, эндокардита, инфекции центральных венозных катетеров и сепсиса..
Moraxella atlantae
Он был найден едва ли при бактериемии.
Моракселла Канис
Это часть верхних дыхательных путей собак и кошек. У человека было обнаружено бактериемия и инфекция ран после укуса собаки.
Поскольку эти виды были очень чувствительны к пенициллину, антибиограмма не требовалась. Тем не менее, известно, что с 1990 года большинство штаммов, особенно видов catarrhalis, являются производителями бета-лактамаз.
Поэтому желательно провести тесты на чувствительность к противомикробным препаратам. Но эту работу сложно выполнить, поскольку в CLSI не указаны точки среза для жанра. Moraxella, что мешает его интерпретации.
По этой причине в некоторых лабораториях используются точки разреза, описанные для Haemophilus influenzae или для беспокоящих бактерий, которые могут расти в средах Мюллера-Хинтона без добавок, или для неферментирующих грамотрицательных бактерий.
Штаммы Moraxella catarrhalis часто чувствительны к хинолонам, амоксициллин-клавулановой кислоте, цефалоспоринам, тикарциллину, пиперациллину, макролидам, хлорамфениколу и аминогликозидам.
Однако сообщалось о штаммах, устойчивых к тетрациклину, эритромицину, фторхинолону, макролидам, пиперациллину и некоторым цефалоспоринам..
Читайте также:
